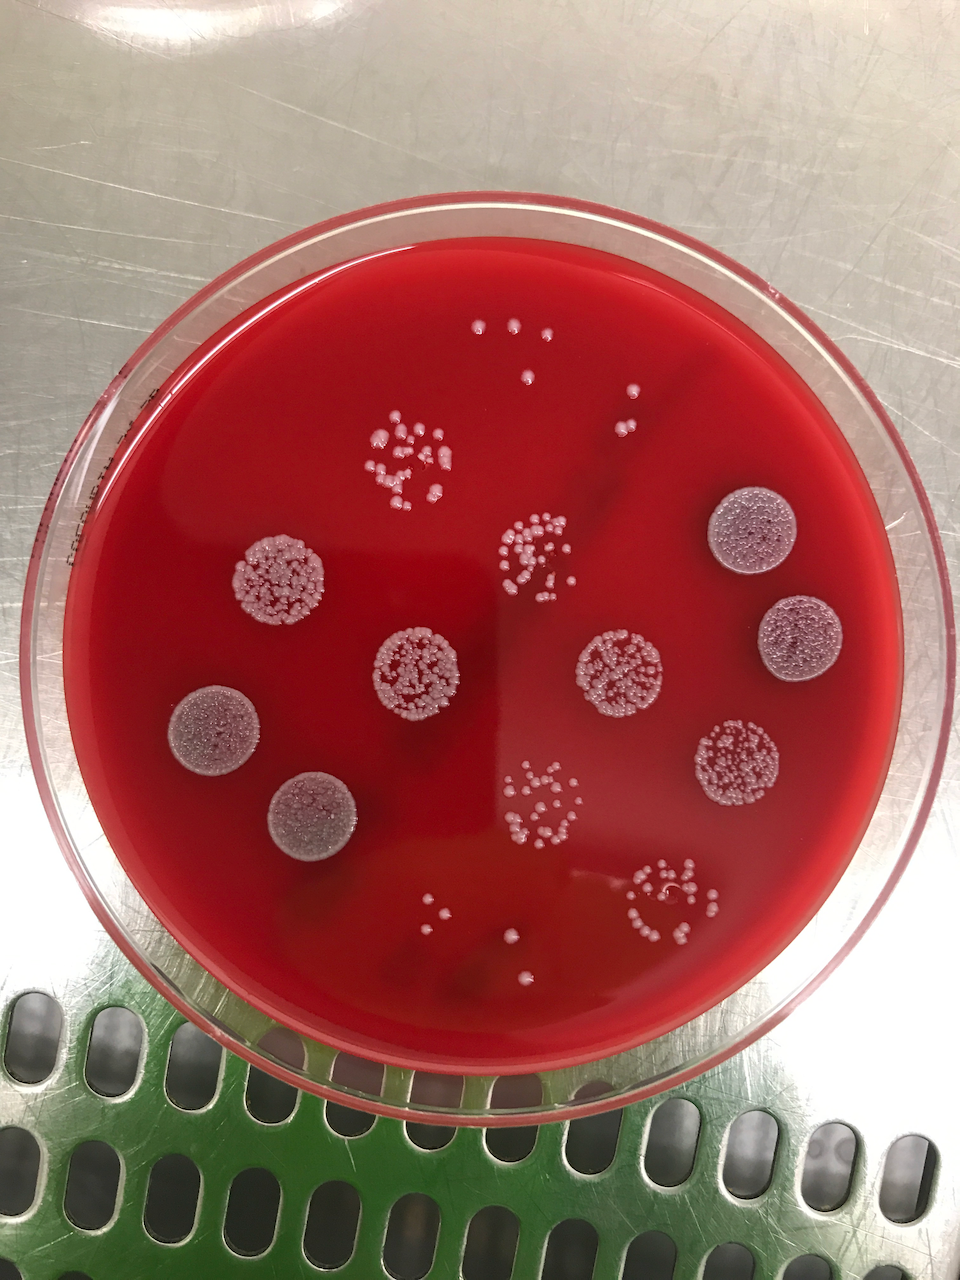

Team

Lucas Boeck
Group Leader. Lucas is an Austrian clinician-scientist and specialist in Internal and Pulmonary Medicine. Following postdoctoral research at the Wellcome Sanger Institute and Laboratory of Molecular Biology in Cambridge (UK), he is Consultant in Pulmonary Medicine at the University Hospital Basel and leads pulmonary infection research at the Department of Biomedicine. Operating at the interface of fundamental biology and patient care, he seeks to change how antibiotic responses are measured and translated to improve infection therapy.

Sergio Cheng
MSc student. Sergio is originally from Tenerife (Spain), where he grew up before moving to Barcelona to study Biotechnology at the Universitat de Barcelona (UB). He did a research internship at the CSIC, which got him interested in working with microorganisms. After his Bachelor's, he came to Basel for his Master's in Molecular Biology and joined the Boeck lab for his thesis project. He works on expanding high-throughput antimicrobial susceptibility testing (ASCT) to new bacterial species, combining single-cell microscopy with deep-learning-based image analysis pipelines. When he's not in the lab, he's usually out hiking or doing sports.

Greta Giannini
PhD student. Greta holds a B.Sc. in Biotechnology from the University of Milano-Bicocca and an M.Sc. in Quantitative Biology from the University of Milano-Statale. During her Master’s thesis in the laboratory of Beatrice Bodega, she explored epigenetic mechanisms of T cell differentiation through LINE1-mediated liquid–liquid phase separation, developing a lasting enthusiasm for imaging and quantitative data analysis. She later transitioned into microbiology in the laboratory of Fernanda Pinheiro, where she worked on modelling evolutionary trajectories in interacting auxotrophic E. coli strains. In 2025, she joined the Boeck Lab in Basel to investigate antibiotic responses in mycobacteria at the single-cell level. Integrating high-throughput drug screening, time-lapse microscopy, and computational analysis, she studies how bacterial populations heterogeneously respond to antimicrobial stress. She is motivated by the challenge of improving treatment strategies for tuberculosis and NTM infections while extracting biological mechanisms from complex single-cell data. Outside the lab, she balances her enthusiasm for adrenaline-filled sports with quieter moments outdoors, often exploring nature with her dogs and cats.

Giulian Meier
MSc student. Giulian completed his BSc in Organismic Biology at the University of Basel and is currently a Master student of Infection Biology in Boecks lab. He is interested in the potential of the new live-cell imaging pipeline called ASCT in drug research. Using ASCT, he investigates the killing potential of a new drug candidate in combination therapy against Mycobacterium abscessus. Outside the lab, he enjoys going to the gym, cooking, and maintaining an active lifestyle.

Anna Menon
PhD student. Anna obtained her B.Sc. in Biological Sciences and a Master’s degree in Molecular Cell Biology from the University of Bologna (IT). During her Master’s thesis at the University of Leicester (UK), she investigated the impact of SpnIII type I RM systems on gene expression in Streptococcus pneumoniae. She then joined the IRB Institute of Bellinzona (CH) as a pre-doctoral fellow, where she worked on antibody discovery and the regulation of inflammatory responses in human T cells. After this period in immunology, she decided to return to her primary interest in microbiology and bacterial research. In 2025, she joined the Boeck lab as a PhD student to identify novel genetic drug targets for the development of new therapies against mycobacteria. Outside the lab, she enjoys traveling and can often be found on a train or plane visiting friends across Europe.

Francesca Nicola
PhD student. Francesca earned her BSc in Biotechnology from the University of Piemonte Orientale and her MSc in Biotechnology and Medical Biology from San Raffaele University (Milan). Following a Master’s thesis in medical genetics, she transitioned to microbiology at the Emerging Bacterial Pathogens Unit (San Raffaele Hospital), where she completed a research fellowship before starting her PhD. Her doctoral research focuses on host-pathogen interactions at the mucosal level, utilizing both in vitro and in vivo models of Mycobacterium abscessus infection. She applies omics approaches to gain a deeper understanding of these complex relationships. She is currently a visiting researcher at the Boeck Lab, evaluating macrolide efficacy using advanced ALI (Air-Liquid Interface) lung models. Outside the lab, she is an active runner and volleyball player who loves hiking, traveling, and the art of baking.

Michelle Roulier
PhD student. Michelle’s research interests lie in host-microbe interactions. She earned her MSc in Biology at ETH Zurich, where she investigated plant immune responses to endogenous microbiota. Returning to her hometown of Basel for her PhD, she transitioned this interest towards human pathogens and the challenges of antibiotic therapy. Within the NCCR AntiResist initiative, she focuses on the opportunistic pathogen Pseudomonas aeruginosa. She is particularly passionate about developing novel experimental approaches to uncover why antibiotic treatments fail. In her free time, Michelle likes to stay active through running and hiking, and she enjoys bringing people together by cooking and hosting dinners.
They were part of our journey
Santiago Muniz
Basil Wicki, PhD 2024
Alex Jovanovic, MSc 2021, PhD 2025
Frederick Bright, PhD 2024
Ahmad Sadeghi
Sara Toprak, MSc 2025
Anna Rodoni, MSc 2023
Melis Kir, MSc 2023
Guendalina Gherardini
Andreas Wüst
Gallery